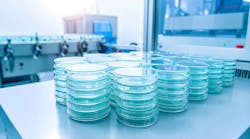
adobestock_1671577323 adobestock_1671577323

Featured Articles
ID 31057331 © Warrengoldswain | Dreamstime.com
ID 78982552 © Tashatuvango | Dreamstime.com
ID 13004272 © Ragsac19 | Dreamstime.com
ID 255091942 © Luisfilipemoreira | Dreamstime.com
ID 196360130 © Alphaspirit | Dreamstime.com
ID 292617035 © Sheila Fitzgerald | Dreamstime.com
ID 265875695 © Lightfieldstudiosprod | Dreamstime.com
ID 56463226 © Aviahuismanphotography | Dreamstime.com
ID 56692654 © Sudok1 | Dreamstime.com
NYU Langone Hospital—Long Island
Sign up for our eNewsletters
Get the latest news and updates
Learning Resources
Sponsored
Dec. 18, 2025
Sponsored
Dec. 11, 2025